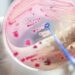
Inventai01

台灣微軟新任總經理卞志祥舉辦媒體見面會暢談領導團隊方針,更分享接下來對台灣微軟的展望與規劃,包括如何持續在台灣落實微軟使命,從賦能產業的數位轉型迎向下一步:Digital Imperative 數位轉型、勢在必行的五大轉型的數位關鍵。
深耕在地產業經驗,卞志祥累積跨領域以及跨產業歷練,掌舵台灣微軟
從求學時期到步入職場,卞志祥首度分享自己成長歷練以及轉型的腳步。畢業於國立交通大學、主修計算機科學,並同時在該校取得管理資訊系統/財務工程企管碩士學位,他清楚認知到自己不只擁有對程式設計的熱情,更具備將複雜問題簡化並訂出戰略目標的能力,同時他也意識到自己在邏輯與溝通等方面有良好表現,因此在求學生涯中做出跨出舒適圈的決定。
出社會後,卞志祥的工作經驗更是橫跨財務、行銷、業務及服務等範疇,不僅在加入微軟之前,曾任湯森路透台灣區總經理及北亞區董事,引進全球金融市場多樣化的交易資訊外,也曾於Hewlett-Packard台灣分公司擔任資深副總、磨練管理能力,都讓卞志祥擁有豐富的在地化市場觀察與服務經驗,將有助於台灣微軟在未來深耕在地市場的需求。
「賦能地球上的每一個人和每一個組織,都能實現更多,成就非凡。」卞志祥表示就是看到微軟CEO Satya Nadella 薩帝亞納德拉上任之後,擬定新的使命,開始認同並佩服薩帝亞的遠見與微軟遠大的使命感,他也於 2017 年時加入台灣微軟領導團隊,擔任大型企業商務事務群總經理。
以五大轉型數位關鍵,賦能產業垂直深化與水平擴張
卞志祥不僅在台灣微軟大型企業商務事務群時曾創下兩倍業績成長的優異表現,帶動數據和資安產業解決方案的銷售增長,他個人的產業經驗更橫跨金融、電信、資訊科技和醫療服務,以豐富的產業經驗,他洞察產業需求,提出將以「Digital Imperative 數位轉型、勢在必行」為核心,輔以五大轉型數位關鍵協助產業,持續迎戰後疫情時代。
一、產業上雲
微軟與在地不同領域如政府、金融、製造、醫療的客戶合作,協助將資料上雲,加速數位轉型的步調、實現安全智慧工作模式、全方位賦能員工提高生產力,同時透過上雲降低碳排放量,為淨零碳排永續願景貢獻心力。
二、賦能開發團隊
賦能開發團隊是微軟一直以來希望協助企業實現的目標,微軟期待 2025 年時超過70%的企業應用程式可以使用低程式碼或無程式碼工具。同時也不斷推出相關優化工具,包含:Power Platform,希望企業使用這個低程式碼的工具平台有效建置屬於組織的解決方案,並相對其他企業節省超過 80% 以上的成本。
三、AI 模型與數據整合
為了讓企業能省去數據整合的時間並運用其產生更多產值,微軟也持續在 Azure 平台上建立不同模型,成為企業在不同情況下的最佳解決方案,並整合雲端大數據。
四、協同合作商議模式
微軟觀察到協作模式已成為現在不可或缺的合作方式。為此,除持續在 Microsoft 365 與 Microsoft Teams 加入多項新功能,讓使用者可以隨時隨地投入於工作中,今年更全新推出員工體驗平台 Microsoft Viva 使企業溝通更順暢,大幅提升工作效率。
五、資安優先
隨著攻擊的手法不斷推陳出新,在產業上雲過程,資訊安全更應重視,微軟為企業提供最安全先進的資料處理平台,保護數據安全。
同時,卞志祥也分享微軟接下來針對金融、醫療、製造業等產業,基於永續發展的角度將有更多垂直深化與水平擴張的佈局。他直言,未來五年微軟在台灣將會持續深耕,同時擴展賦能產業的力道,不僅現有的產業將出現解構跟跨域整合的態勢,微軟也希望鏈結夥伴生態系、新創團隊及客戶,做到水平擴張,讓微軟能真正賦能每一個需要轉型的夥伴。
展望未來,卞志祥表示台灣不僅擁有優質的人才,也是全球極為少數、能整合軟硬體的科技重鎮,更重要的是、根基於 ICT 與半導體產業作為後盾,台灣能以絕佳韌性串接全球供應鏈的強大量能,而這都是微軟在這些年深耕台灣市場看到的在地優勢。面對全球市場環境的不確定因素,台灣微軟將持續善用數位工具以及創新科技,持續賦能客戶,夥伴以及台灣產業加速轉型,實現更多和成就非凡。